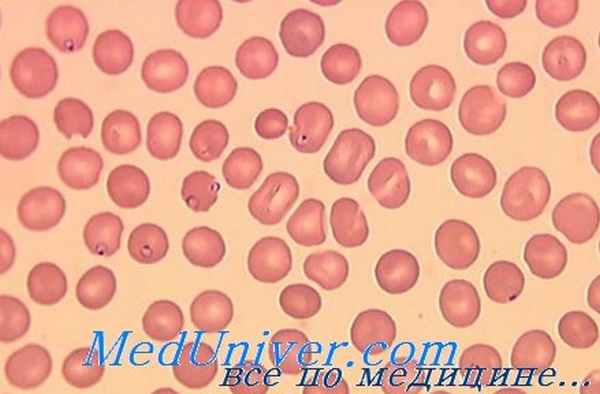
анемия у больной

Болезнь Риетти—Греппи—Микели. Серповидноклеточная анемия.
Добавил пользователь Alex Обновлено: 08.01.2026
Болезнь Риетти—Греппи—Микели. Серповидноклеточная анемия.
Термином thalassemia minor [болезнь Риетти— Греппи— Микели (Rietti—Greppi—Micheli)] обозначают картину болезни, отличающуюся от анемии Кули отсутствием эритробластоза в остальном при такой же симптоматологии, но с хорошим прогнозом, ввиду чего она наблюдается также у взрослых. Более легкие случаи, при которых все симптомы очень слабо выражены, описаны под названием thalassaemia minima (Gatto).
Несмотря на низкое содержание гемоглобина, иногда как выражение чрезмерной компенсации имеется полиглобулия.
Согласно новейшим исследованиям (Silvestroni,Gatto, Heinle и Read), как thalassaemia major, так и minor обусловливаются теми же конституциональными факторами, причем гетерозиготная наследственность дает синдром Риетти — Греппи — Микели, а гомозиготная — анемию Кули.
Серповидноклеточная анемия описана почти исключительно у негров, наследуется по доминантному типу и характеризуется серповидной формой эритроцитов и мишеневидными клетками (target-cells) в периферичес кой крови. Однако эти эритроциты, названные дрепаноцитами, в обычном мазке крови не видны, они образуются только после устранения доступа кислорода. Для этой цели смесительной пипеткой для эритроцитов наносят одну каплю под покровное стекло, заливают по краям парафином для предотвращения доступа воздуха и ставят в термостат. Через 24 часа можно наблюдать образование серповидных форм.
Клинически серповидноклеточная анемия дает симптоматологию гемолитических анемий. Кризы обычно сопровождаются тромбозами в различных органах, причем на первый план выступают боли в животе и суставах, а также язвы голеней. Часто ставится ошибочный диагноз ревматического полиартрита.
Причина серповидноклеточной анемии — мутация гена, приводящая к образованию ненормального гемоглобина (так называемого гемоглобина S), который можно выявить с помощью электрофореза. Молекулы гемоглобина S серповидной клетки при утрате ими кислорода могут образовать серповидные клетки. Носители гетерозиготной наследственной склонности образовывать серповидные клетки заметно резистентнее к малярии, так что высокую частоту такого гена у негров можно объяснить избирательным действием малярии (Allison).
Эллипсоцитоз (овальноклеточная анемия) может в отдельных случаях также вести к умеренной гемолитической анемии. Однако все гемолитические симптомы очень легкие; в большинстве случаев доминантно наследуемая, не связанная с полом овальная или эллипсоидная форма эритроцитов не имеет клинического значения.
Решающее значение для диагностики имеет нахождение эллипсоидных эритроцитов (см. рис. 47), процент которых в норме не более 10, а при вполне развившейся болезни может достигать 70—90% всех эритроцитов (Heilmeyer).
С-гемоглобиновая болезнь. При этой редкой, наблюдаемой только среди негров, наследственной анемии особенно многочисленны мишеневидные клетки, что обусловливается ненормальным С-гемоглобином, который определяется электрофорезом (Hartz и Schwartz).
В последние годы в небольшом числе случаев наблюдались еще другие формы гемолитической анемии, причем не во всех случаях точно установлено, действительно ли речь идет об особых заболеваниях.
Макроцитарная семейная гемолитическая анемия типа Хадена (Haden) характеризуется макроцитозом, обилием клеток с базофильной лунктацией и нормальной осмотической резистентностью.
Наследственная, связанная с полом, гемолитическая анемия Rundler и Falls (Cooley) — это гипохромная микроцитарная анемия со спленомегалией, сходная в некотором отношении с талассемией. Однако женщины никогда не поражаются: они только передают анемию по наследству.
Наследственная, нешаровидноклеточная гемолитическая анемия Крозби (Crosby): нормальная осмотическая резистентность. Ее осо бенность: наличие в моче близкого к уропорфирину вещества — порфиробилиногена.
Конституциональная гиперхромная овальноклеточная анемия Фанкони (Fanconi): обращает на себя внимание похожая на пернициоз ную анемию картина крови с очень большими овальными (эллипсовидными) формами.
- Вернуться в оглавление раздела "Профилактика заболеваний"
Информация на сайте подлежит консультации лечащим врачом и не заменяет очной консультации с ним.
См. подробнее в пользовательском соглашении.
анемия серповидно-клеточная
2) Medicine: crescent cell anemia, sickemia, sickle cell anemia, sickle-cell disease (дрепаноцитарная, менискоцитарная) , sicklemia (дрепаноцитарная, менискоцитарная) , sicle-cell disease, sickle cell anaemia
2 серповидно-клеточная анемия
med. Drepanozyt -Anämie, Drepanozyten -Anämie, Sichelzell -Anämie, Sichelzellanämie, Sichelzellen -Anämie, Sichelzellenanämie
3 серповидно-клеточная анемия
4 серповидно-клеточная анемия
5 серповидно-клеточная анемия
6 серповидно-клеточная анемия
7 серповидно-клеточная анемия
8 серповидно-клеточная анемия
9 анемия
аутоиммунная гемолитическая анемия с комбинированным синдромом холодовых и тепловых агглютининов — combined cold-warm-antibody autoimmune hemolytic anemia
апластическая анемия, вызванная инфекцией — aplastic anemia induced by infection
апластическая анемия, вызванная лекарственными средствами — aplastic anemia induced by drugs
апластическая анемия, вызванная облучением — aplastic anemia induced by radiation
субтропическая мегалоцитарная анемия беременных — subtropic megalocyte pregnant anemia, Wilis-Balfur-MacSwini syndrome
наследственная гипопластическая анемия Блекфана-Даймонда — congenital hypoplastic anemia, Diamond-Blackfan syndrome
анемия, врождённая вследствие изоиммунизации — congenital anemia due to isoimmunization
анемия, врождённая вследствие потери крови плодом — congenital anemia due to fetal blood loss
врождённая анемия, вызванная гипоплазией красных кровяных клеток — congenital anemia induced by red blood cells hypoplasia
анемия, вызванная аминокислотной недостаточностью — amino acid deficiency anemia
анемия, вызванная атмосферным давлением — atmospheric pressure anemia
анемия, вызванная белковой недостаточностью — protein deficiency anemia
анемия, вызванная избирательным нарушением всасывания витамина В12 с протеинурией — selective malabsorption of vitamine B12 anemia with proteinuria
анемия, вызванная нарушением глутатионового обмена — glutathione metabolism disturbance-induced anemia
анемия, вызванная недостаточностью гексокиназы — hexokinase deficiency anemia
анемия, вызванная недостаточностью глицеральдегидфосфатдегидрогеназы — glyceraldehyde phosphate dehydrogenase deficiency anemia
анемия, вызванная недостаточностью глутатиона эритроцитов — erythrocytic glutathione deficiency anemia
анемия, вызванная недостаточностью глутатионредуктазы — glutathione reductase deficiency anemia
анемия, вызванная недостаточностью глюкоза-6-фосфат-дегидрогеназы — glucose-6-phosphate dehydrogenase deficiency anemia
анемия, вызванная недостаточностью 2,3-дифосфогликуратмутазы — 2,3-diphosphoglycurate mutase deficiency anemia
анемия, вызванная недостаточностью железа — iron-deficiency [asiderotic] anemia
анемия, вызванная недостаточностью пируваткиназы — pyruvate kinase deficiency anemia
анемия, вызванная недостаточностью питания — nutrition deficiency anemia
анемия, вызванная недостаточностью солей фолиевой кислоты — folic acid salts deficiency anemia
анемия, вызванная недостаточностью триозофосфатизомеразы — triosephosphate isomerase deficiency anemia
анемия, вызванная недостаточностью фолатов — folates deficiency anemia
анемия, вызванная недостаточностью фолиевой кислоты — folic acid deficiency anemia
анемия, вызванная недостаточностью фосфоглицераткиназы — phosphoglycerate kinase deficiency anemia
анемия, вызванная недостаточностью 6-фосфоглюконатдегидрогеназы — 6-phosphogluconate dehydrogenase deficiency anemia
анемия, вызванная недостаточностью фосфофруктоальдолазы — phosphofructoaldolase deficiency anemia
острая анемия, вызванная потерей крови — hemorrhagic [acute posthemorrhagic] anemia, acute anemia due to blood loss
анемия, вызванная потерей крови плодом — anemia due to fetal blood loss
гемолитическая анемия, вызванная тромботической тромбоцитопенической пурпурой — hemolytic anemia induced by thrombotic thrombocytopenic purpura
гемолитическая анемия, вызванная ферментной недостаточностью — enzyme deficiency induced hemolytic anemia
гемолитическая анемия, вызванная болезнями сердца — hemolytic anemia induced by heart diseases
гемолитическая анемия, вызванная лекарственными средствами — hemolytic anemia induced by drugs
гемолитическая анемия, вызванная шунтом или другим внутренним протезным приспособлением — hemolytic anemia induced by shunt or other internal prosthesis device
гемолитическая микросфероцитарная анемия — hereditary spherocytosis, globular cell anemia, congenital hemolytic [chronic familial] icterus, (chronic) alcoluric jaundice, Minkowsky-Shauffard disease
гемолитическая с анемия Rho-фенотипом — Rho disease, Rh deficiency syndrome
гемолитическая эллиптоцитарная анемия — hemolytic ellyptocytary [ellyptocytotic] anemia, elliptocytosis
гемолитическая анемия новорождённых — hemolytic anemia of newborn, neonatal anemia
алиментарная мегалобластная анемия при недостаточном всасывании железа — alimentary [nutritional] megaloblastic anemia due to iron malabsorption
алиментарная мегалобластная анемия при уточнённой недостаточности питания — alimentary [nutritional] megaloblastic anemia due to defined nutrition deficiency
гипохромная анемия, связанная с депонированием железа — hypochromic anemia connected with iron depositing
макроцитарная анемия, связанная с питанием — nutritional macrocytic anemia, macrocytic anemia due to nutrition
мегалобластная анемия, связанная с питанием — nutritional megaloblastic anemia
семейная гипохромная анемия, связанная с полом — familial hypochromic sex-linked anemia
гемолитическая анемия Странски-Регала — Stransky-Regala hemolytic anemia, hemoglobinopathy
хроническая анемия, вызванная кровотечением — chronic anemia due to blood loss, chronic posthemorrhagic anemia
10 D57.0
11 D57.1
12 СКА
13 мутация
редкое спонтанное (естественное) или искусственно вызываемое с помощью мутагенов (см. мутаген) наследуемое изменение в нуклеотидной последовательности нуклеиновой кислоты, ответственной за хранение и передачу генетической информации организма. М. — единственный источник новых наследственных изменений. По характеру изменения генетического аппарата М. делят на геномные, хромосомные и генные. Геномные М. заключаются в изменении числа хромосом в клетках организма; к ним относятся: полиплоидия (см. полиплоидия), гаплоидия (см. гаплоидия), анеуплоидия (см. анеуплоидия). Хромосомные мутации (хромосомные аберрации) разделяют на внутрихромосомные и межхромосомные. К внутрихромосомным мутациям относятся инверсии (см. инверсия), транслокации (см. транслокация), делеции (см. делеция), дупликации (см. дупликация) и др. К межхромосомным М. относятся транслокации — обмен участками между двумя хромосомами. Если при этом происходит слияние двух остатков хромосом, каждый из которых содержит центромеру, возникает дицентрическая хромосома (дицентрик). При обмене участками двух плечей одной и той же хромосомы со слиянием ее проксимальных концов образуется кольцевая хромосома. Генные М. чаще всего связаны либо с заменой пары азотистых оснований в полинуклеотидной цепи ДНК, что было впервые установлено в случае такой патологии человека, как серповидно-клеточная анемия, или со вставкой, или с выпадением нескольких отдельных нуклеотидов, характерных для мутаций типа сдвига "рамки считывания" (см. рамки считывания сдвиг). М. называют прямой (см. прямая мутация), если ее проявление приводит к отклонению признака от дикого типа, и обратной (см. реверсивная мутация), когда ее проявление приводит к полному или частичному восстановлению фенотипа дикого типа. М., возникающая в половых клетках или клетках полового зачатка, называется генеративной, а в клетках других тканей — соматической. Генеративная М. проявляется в следующем поколении в виде изменения фенотипа всего организма и передается последующим поколениям. Действие соматической М. при ее возникновении на ранних стадиях эмбриогенеза ведет к появлению пороков развития. Соматическая М. может также играть роль одного из пусковых механизмов развития опухолей. Термин "М." предложен Х. Де Фризом в 1901 г.
См. также в других словарях:
АНЕМИЯ СЕРПОВИДНО-КЛЕТОЧНАЯ — мед. Серповидно клеточная анемия наиболее часто регистрируемая наследственная гемоглобинопатия, характеризующаяся умеренно выраженной хронической гемолитической анемией, рецидивирующими острыми болевыми кризами и повышенной восприимчивостью к… … Справочник по болезням
анемия серповидно-клеточная — (a. meniscocytica; син.: А. дрепаноцитарная, А. менискоцитарная) наследственная гемолитическая А., обусловленная наличием в эритроцитах патологического гемоглобина S; в условиях гипоксемии такие эритроциты приобретают серповидную форму … Большой медицинский словарь
Серповидно-клеточная анемия — Серповидный эритроцит МКБ 10 D57. МКБ 9 … Википедия
АНЕМИЯ — (от греч. an отрицат. приставка и кровь) (малокровие), группа заболеваний, характеризующихся уменьшением кол ва эритроцитов и (или) гемоглобина в крови, что приводит к гипоксии. Причины: кровопотери (острые и хронич. постгеморрагич. А.), повыш.… … Естествознание. Энциклопедический словарь
Дрепаноцитарная анемия — Серповидно клеточная анемия Серповидный эритроцит МКБ 10 D57. МКБ 9 … Википедия
Гемолитическая анемия — МКБ 10 D55 D59 МКБ 9 282282, 283283, 773 … Википедия
Анеми́я — (anaemia; Ан + греч. haima кровь; син. малокровие) состояние, характеризующееся снижением содержания гемоглобина в единице объема крови, чаще при одновременном уменьшении количества эритроцитов. Анемия агастрическая (a. agastrica) железо и (или)… … Медицинская энциклопедия
Болезнь Геррика — Серповидно клеточная анемия Серповидный эритроцит МКБ 10 D57. МКБ 9 … Википедия
Болезнь Херрика — Серповидно клеточная анемия Серповидный эритроцит МКБ 10 D57. МКБ 9 … Википедия
Дрепаноцитоз — Серповидно клеточная анемия Серповидный эритроцит МКБ 10 D57. МКБ 9 … Википедия
Менискоцитоз — Серповидно клеточная анемия Серповидный эритроцит МКБ 10 D57. МКБ 9 … Википедия
Талассемия (средиземноморская анемия)
В основе развития талассемий лежит точечная мутация или делеция структурных генов, ответственных за синтез цепей глобина. По генетическому механизму талассемии разделяют на гомозиготные и гетерозиготные. При гомозмготных формах имеется мутация всех генов талассемии, что приводит к полной блокаде синтеза соответствующей цепи глобина. При гетерозиготных формах наряду с геном талассемии имеется и здоровый парный ему ген, в результате синтез цепи глобина блокирован частично. Гомозиготные талассемии предопределяют более тяжелое течение заболевания.
Полное или частичное нарушение синтеза одной из цепей глобина приводит, с одной стороны, к нарушению гемоглобинизации эритроцитов, с другой – к гемолизу и неэффективному эритропоэзу.
Различают α-, β-, δ-, и γ-талассемию.
β-талассемия – это наиболее распространенная форма талассемии, обусловленная снижением продукции β-глобиновых цепей.
Блокада β-цепей глобина приводит к избытку α-цепей глобина, снижению образования нормального гемоглобина (HbA,α2β2) и повышенному образованию фетального гемоглобина (HbF,α2γ2) и НЬА2 (α2δ2).
Недостаточный синтез β-цепей приводит к избыточному образованию α-цепей. Лишние γ-цепи способствуют появлению нестабильного гемоглобина, который преципитирует и выпадает в эритроците в виде «телец включения», придавая им форму мишеней. Кроме того, образующиеся в избытке α-цепи вступают в соединение с SH-группами мембраны и повышают ее проницаемость, нарушаются процессы ассимиляции железа и синтеза гемоглобина. Это обусловливает раннюю гибель эритроцитов в результате внутриклеточного гемолиза с развитием гипохромной анемии.
Патогенез β-талассемии рис. 3.

Рисунок 3 – Схема патогенеза талассемии (на примере β-талассемии )
Выделяют три формы β-талассемии: малая (болезнь Риетти – Греппи – Микели), помежуточная талассемия, большая талассемия (болезнь Кули, средиземноморская анемия).
Развернутая картина тяжелой гемолитической анемии возникает при гомозиготном наследовании нарушения синтеза β-цепей — болезни Кули, проявляющейся физическим и умственным недоразвитием, бледной желтушной окраской кожи с признаками гемосидероза, придающего коже зеленовато-коричневый оттенок, деформацией костей черепа (башенный череп, увеличение верхней челюсти, нарушение прикуса; на рентгенограмме — расширение костномозгового канала трубчатых костей, поперечная исчерченность плоских костей черепа — игольчатый периостоз), язвами нижних конечностей, выраженной гепато- и спленомегалией.
Картина периферической крови:
гипохромная микроцитарная анемия, степень выраженности которой зависит от формы талассемии;
анизоцитоз эритроцитов за счет микроцитов;
пойкилоцитоз за счет мишеневидных эритроцитов;
гипохромия эритроцитов, полихроматофилия, базофильная зернистость;
увеличение содержания сидероцитов;
количество лейкоцитов и тромбоцитов – в пределах нормы.
Исследование костного мозга: костный мозг гиперклеточный, преобладают клетки красного ряда, содержание сидеробластов увеличено.
Биохимический анализ крови – наблюдается гипербилирубинемия, повышение сывороточного железа, ферритина, активности ЛДГ в сыворотке крови.
Осмотическая резистентность эритроцитов при талассемии повышена
Электрофорез гемоглобинов. Для постановки диагноза и уточнения форм талассемии применяется количественное определение разных типов гемоглобина при помощи электрофореза на ацетатцеллюлозе.
Рентгенологическое исследование скелета: деформация костей скелета по данным рентгенографии
Группы эритроцитов по степени эксцентричности (Е)
Присутствие овалоцитов II группы может обнаруживаться в незначительном количестве — не более 5—10% и у нормальных лиц. При наследственном овалоцитозе преобладают овалоциты III и IV групп.
Признак овалоцитоза наследуется по доминантному типу независимо от группы крови и ее резус-принадлежности. Продолжительность жизни овалоцитов в организме здорового носителя и при переливании донорам не отличается от нормальной. По данным большинства авторов, овальная форма возникает в безъядерных эритроцитах, в токе циркулирующей крови. Костномозговые эритробласты имеют круглую форму; лишь нормобласты в конечной фазе насыщения гемоглобином могут иметь овальную форму (Ю. И. Лорие).
Овалоцитоз — редкая аномалия. Частота ее, по статистическим данным составляет от 1:2500 до 1:3500. Овалоцитоз может наблюдаться и как симптоматическая форма при ряде патологических состояний, главным образом при различных гемолитических анемиях (талассемии, серповидноклеточной, микросфероцитарной), а также при пернициозной анемии. В последнем случае овалоцитоз носит временный, обусловленный характер, исчезая в связи с успешным лечением и наступлением ремиссии.
Как аномалия овалоцитоз в большинстве случаев представляет собой бессимптомное носительство, не дающее каких-либо клинических проявлений. В части случаев—в 12% (по статистическим данным) овалоцитоз сопровождается развитием овалоклеточной анемии (см.).
Овалоклеточная анемия — своеобразная гемолитическая анемия, характерным симптомом которой является выраженный овалоцитоз (эллипсоцитоз) эритроцитов. Овалоцитарная анемия — врожденное состояние, встречающееся в семьях носителей овалоцитоза.
Этиология. Этиология болезни недостаточно изучена. Повсеместное распространение болезни, не ограниченное какой-либо этнической группой или географической зоной, и электрофоретические исследования крови не позволяют отнести овалоклеточную анемию к гемоглобинозам, хотя в ряде случаев был обнаружен фетальный гемоглобин, а отдельные случаи овалоцитарной анемии сочетаются с гемоглобинозами С, S и др.
Известны также случаи сочетания овалоцитоза с нарушением порфиринового обмена.
Семейно-наследственный характер овалоцитоза, прослеженный в ряде случаев, широкий диапазон клинических проявлений — от бессимптомной аномалии до тяжелой гемолитической анемии — позволяют рассматривать эту болезнь как генотипическую аномалию, проявляющуюся с различной экспрессивностью, в зависимости от гетеро- или гомозиготного состояния.
Полагают, что у лиц, гетерозиготных по признаку овалоцитоза, имеет место лишь бессимптомное носительство. Гемолитическая анемия развивается только в случаях гомозиготного носительства, вероятность которого чрезвычайно редка (1:1000000).
Существует и другое предположение, что наличие овалоцитоза, даже в резко выраженной (гомозиготной?) форме, еще не детерминирует анемии. Последняя возникает лишь в том случае, когда одновременно с овалоцитозом имеется другой, генетический дефект, не отражающийся на внешней форме эритроцитов, но обусловливающий развитие гемолиза. В пользу последнего взгляда свидетельствуют случаи сочетанной патологии, в частности наблюдавшийся в нашей клинике больной с врожденным овалоцитозом в сочетании с сидероахрестической анемией, нарушением порфиринового обмена и гемосидерозом печени.
В отдельных случаях, протекающих с увеличением селезенки (вес до 450 г), не исключается роль вторичной гиперсплении в ответ на длительный (многолетний) компенсированный гемолиз.
Картина крови. При овалоклеточной анемии картина крови характеризуется повышенным (до 50% и более) содержанием эритроцитов овальной, эллиптической, иногда палочковидной (бациллярной) формы. Преобладающими формами являются овалоциты III и IV групп. Наибольший — длинный диаметр эритроцитов достигает 12 мкм, наименьший — короткий — 2 мкм. По сравнению с нормальными эритроцитами эритроциты при овалоклеточной анемии обладают пониженной стойкостью к гипертоническим и гипотоническим растворам; они оседают быстрее нормоцитов. Продолжительность пребывания овалоцитов в циркулирующей крови здорового реципиента нормальна.
Осмотическая стойкость овалоцитов нормальна или понижена. В отличие от сфероцитов инкубация не снижает осмотической стойкости овалоцитов.
Клиническая картина. Заболевание отличается большим диапазоном — от компенсированного и даже гиперкомпенсированного (с регенераторным эритроцитозом) гемолиза до тяжелых гемолитических кризов с желтухой, анемией и гепатоспленомегалией. Анемия носит нормохромный гиперрегенераторный (с высоким ретикулоцитозом и выраженным эритронормобластозом костного мозга) характер.
Больным свойственны те же конституциональные аномалии скелета, в частности изменения черепа, а также трофические язвы голени, что и при классической, сфероцитарной форме гемолитической болезни.
Диагноз. Диагноз ставится на основании характерного симптома — выраженного овалоцитоза эритроцитов в сочетании с типичной гемолитической желтухой и анемией.
Отличительной особенностью, позволяющей дифференцировать овалоклеточную анемию от близкой по симптомам врожденной сфероцитарной гемолитической анемии, помимо выраженного овалоцитоза, является отсутствие сфероцитоза и свойственного последнему резкого снижения осмотической стойкости эритроцитов.
От собственно овалоцитарной анемии следует дифференцировать овало(лепто)цитарную гемолитическую анемию Риетти—Греппи—Микели, оказавшуюся малой талассемией.
Течение болезни хроническое, доброкачественное.
Прогноз (quo ad vitam) благоприятный.
Лечение. При гемолитических кризах, сопровождающихся развитием анемии, показаны переливания эритроцитной массы. Радикальное лечение состоит в спленэктомии. Последняя приводит к практическому излечению — ликвидации анемии — при сохраненном овалоцитозе (van den Bergh, 1928; Ю. И. Лорие, 1961, и др.).
Положительные результаты спленэктомии объясняются главной ролью селезенки в разрушении неполноценных эритроцитов. В результате удаления селезенки резко увеличивается длительность пребывания эритроцитов в периферической крови. Так, в случае Blackburn и соавторов средняя «полужизнь» (T1/2 эритроцитов, меченных Сr 51 , составлявшая до операции 4,5 дня, увеличилась до 24 дней после спленэктомии.
Анемия кули. Конституциональные болезни. Адаптационные болезни. Анемия у больного.
Конституциональные болезни. Адаптационные болезни. Анемия у больного.
Конституциональные болезни. Естественно, что дифференциальных признаков, характерных для всей этой группы, за исключением наследственного предрасположения, нет. Однако роль конституции надо учитывать при любом заболевании.
Термином «аутоиммунные» или «аутоагрессивные болезни» в настоящее время объединяют в единую группу те клинические картины, общим признаком которых служит образование аутоантител, т. е. антител, направленных против клеток собственного организма. Этот механизм лежит в основе прежде всего заболеваний крови (гемолитические анемии, лейкопении, тромбоцитопении, панцитопении); возможно, что к ним же относятся и колла генов ые болезни. В диагностическом отношении наиболее важно нахождение с помощью серологических методов антител, причем здесь наибольшее значение приобрела проба К у м б с а.

Адаптационные болезни. Selye под этим термином объединил различные болезни, между которыми до сего времени ясной связи не установлено. Сюда принадлежат узелковый периартериит, нефросклероз, нефроз, гипертоническая болезнь и язвы желудочно-кишечного тракта. Этот термин не нашел еще всеобщего признания. Селье понимает под адаптационными болезнями такие болезни, при которых нельзя найти никаких специфических биохимических или инфекционных причин и при которых после определенных напряженных ситуаций (stress) (главным образом длительные лишения, разочарования и страх) на почве хотя бы и нормальных, но перешедших порог выносливости гормональных влияний (преимущественно минералокортикоидов) дело доходит до патологических картин, которые удалось получить в опытах на животных. В патологии человека не разрешено еще много вопросов. Надо сначала ответить на эти вопросы, чтобы данная группа болезней могла заслужить всеобщее признание, однако она удивительным образом разрешила некоторые ранее трудно понимаемые связи (например, в отношении стресс-язвы после травмы и ожогов).
Под анемией понимают или уменьшение количества эритроцитов ниже нормы, т. е. ниже 4 000 000 у женщин и 4 500 000 у мужчин, или уменьшение содержания гемоглобина ниже нормальных величин (80—90% у мужчин, 70—80% у женщин из расчета 16 г Нb = 100%). Отношение этих величин составляет цветной показатель (ц. п.), который высчитывается следующим образом: содержание гемоглобина делят на число эритроцитов в миллионах, умноженное на 20. Так, например, при 100% гемоглобина и 5 000 000 эритроцитов цветной показатель согласно уравнению
При снижении гемоглобина и неизмененном количестве эритроцитов цветной показатель ниже 1, например 0,8.
Наоборот, цветной показатель выше 1 при высоком содержании гемоглобина, но уменьшенном числе эритроцитов. Уменьшение общего количества циркулирующей крови (олигемия) отнюдь не идентично с понятием анемии.
Хотя эти величины не всегда надежны, однако ввиду легкости расчета цветного показателя он не теряет своего значения для практических целей. Определяя одновременно количество эритроцитов, гемоглобина и гематокрит (в норме для мужчин 40—54%, для женщин 37—47%), можно рассчитать следующие величины, которые дают более надежную основу для подразделения анемий.
- Читать далее "Классификация анемий. Виды анемий."
Оглавление темы "Дифференциальная диагностика. Анемия у больного.":
1. Оценка полученных данных при обследовании больного. Анализ медицинской информации.
2. Дифференциальная диагностика заболеваний. Воспаление в медицине.
3. Признаки опухоли. Признаки аллергии и анафилаксии у больного.
4. Выявление гормональных нарушений. Выявление нейро-вегетативных нарушенй у больного.
5. Конституциональные болезни. Адаптационные болезни. Анемия у больного.
6. Классификация анемий. Виды анемий.
7. Постгеморрагическии анемии. Гемолитические анемии.
8. Приобретенные гемолитические анемии. Первично-ненормальные эритроциты. Кривая Прайс — Джонса.
9. Спленомегалия. Средиземноморская анемия Кули.
10. Болезнь Риетти—Греппи—Микели. Серповидноклеточная анемия.
Читайте также:
